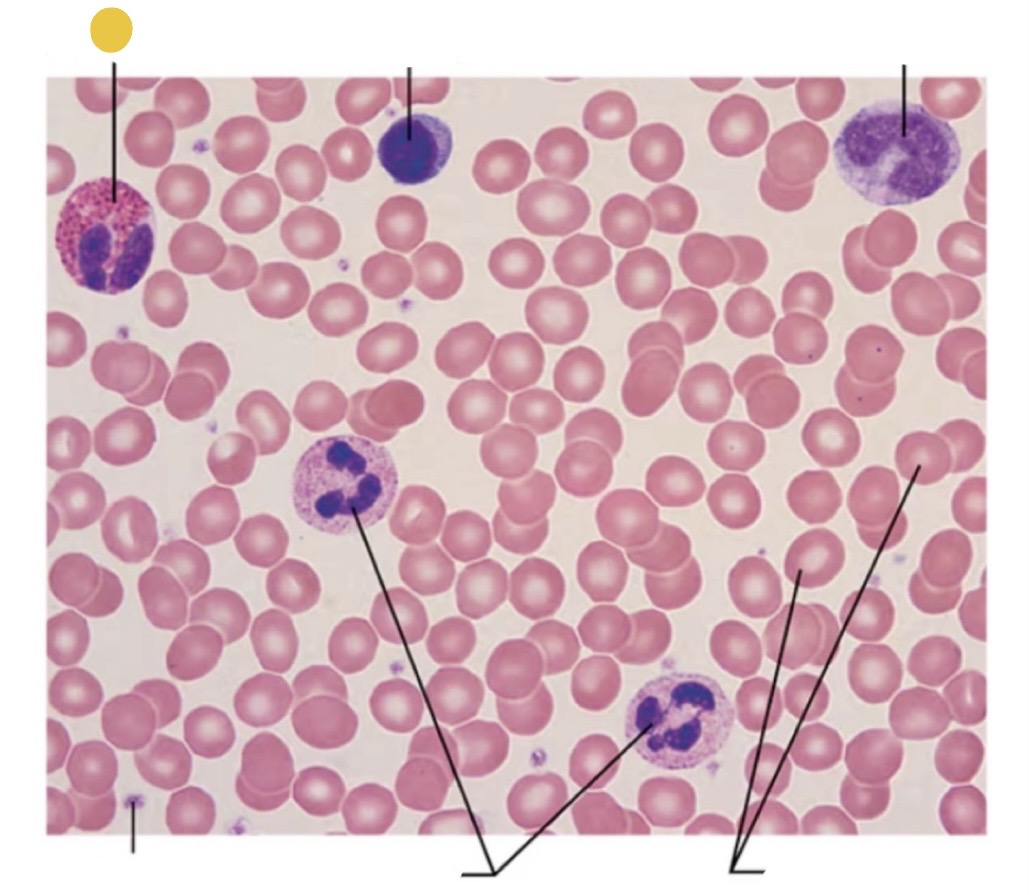
term image
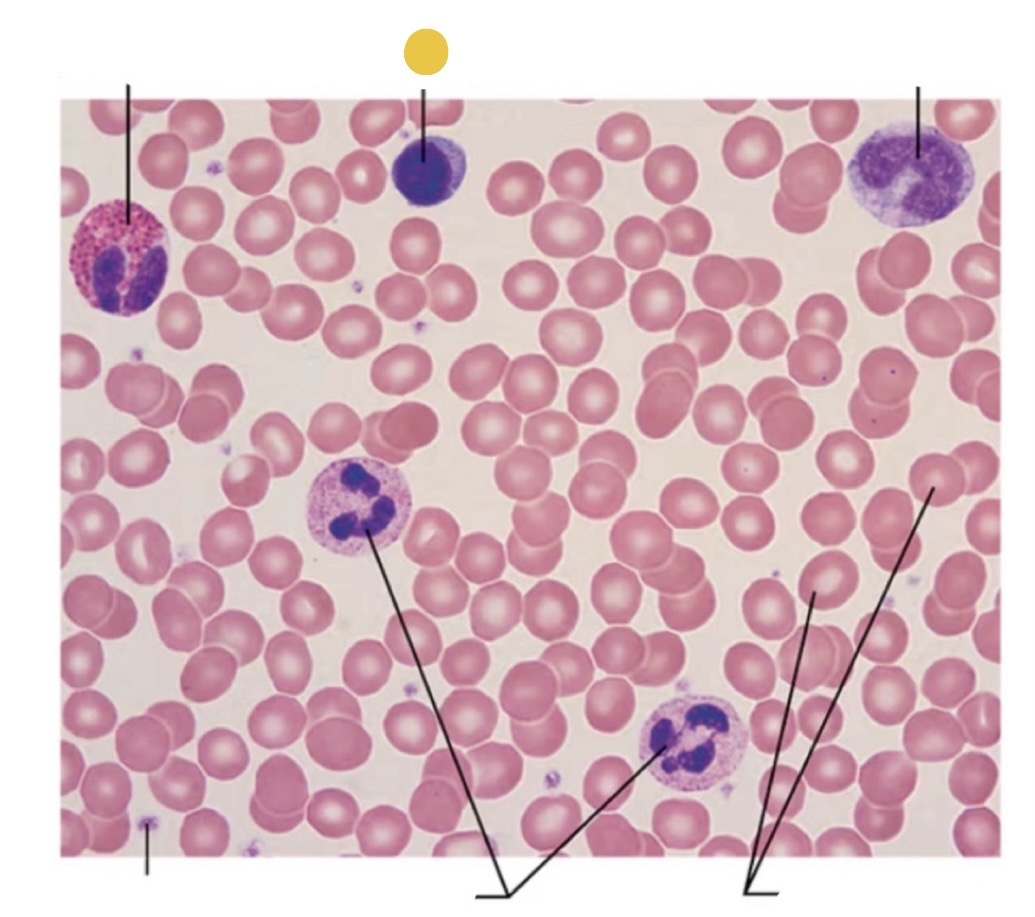
term image
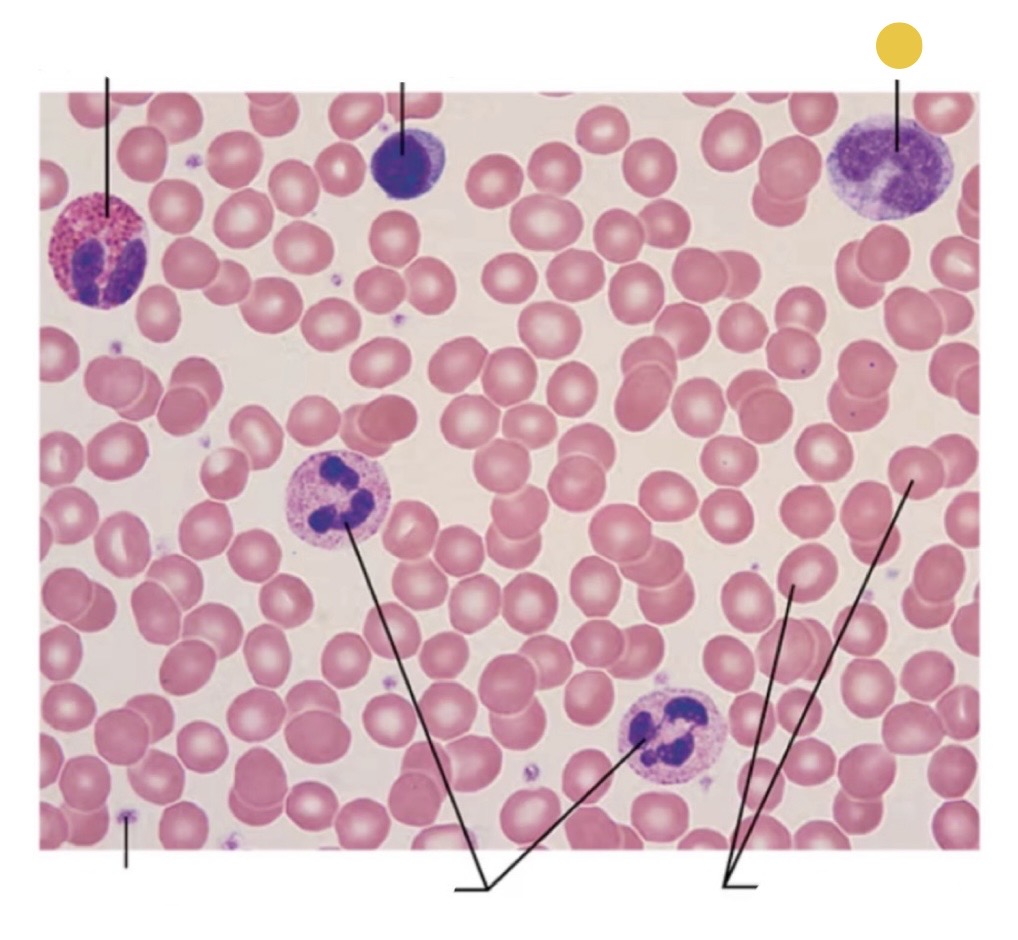
term image
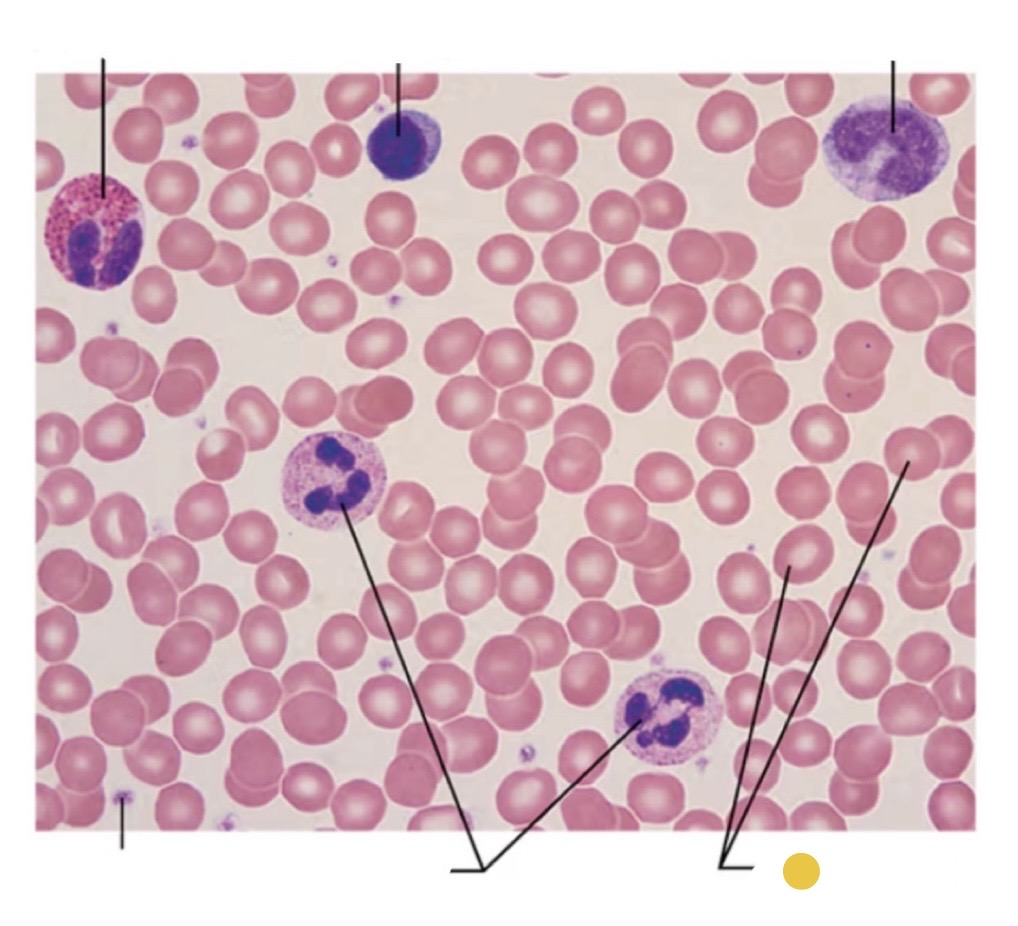
term image
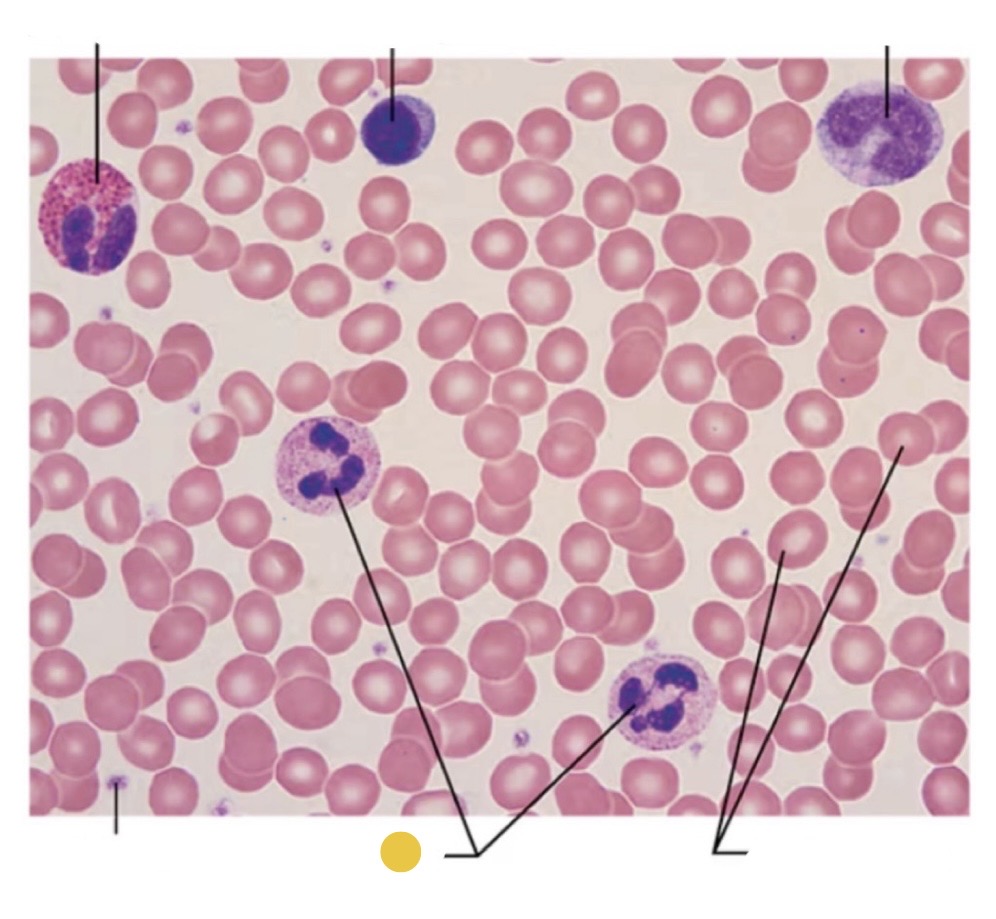
term image
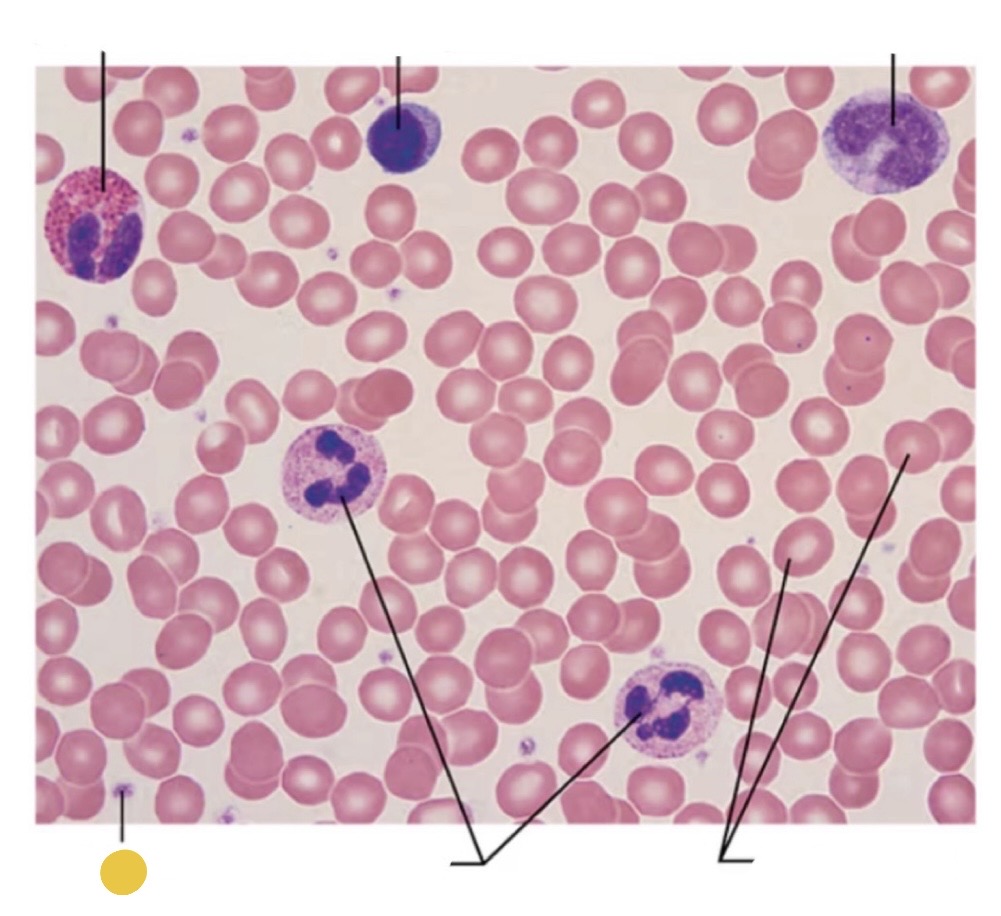
term image

Lymphoid Organ and Lymphocyte Labeling
0.0(0)
Studied by 0 peopleCard Sorting
1/25
There's no tags or description
Looks like no tags are added yet.
Last updated 10:57 PM on 4/11/26
Name | Mastery | Learn | Test | Matching | Spaced | Call with Kai |
|---|
No analytics yet
Send a link to your students to track their progress
26 Terms
1
New cards

afferent lymphatic vessels
2
New cards

cortex
3
New cards

lymphoid follicle
4
New cards

germinal center
5
New cards

efferent lymphatic vessels
6
New cards

hilum
7
New cards

medulla
8
New cards

medullary cord
9
New cards

medullary sinus
10
New cards

trabeculae
11
New cards

trabecula
12
New cards

lymphoid follicles
13
New cards

medullary sinuses
14
New cards

medullary cords
15
New cards

tonsillar crypt
16
New cards

germinal centers in lymphoid follicles
17
New cards
eosinophil
18
New cards
lymphocyte
19
New cards
monocyte
20
New cards
erythrocyte
21
New cards
neutrophils
22
New cards
platelets
23
New cards

red pulp
24
New cards

white pulp
25
New cards

red pulp
26
New cards

white pulp